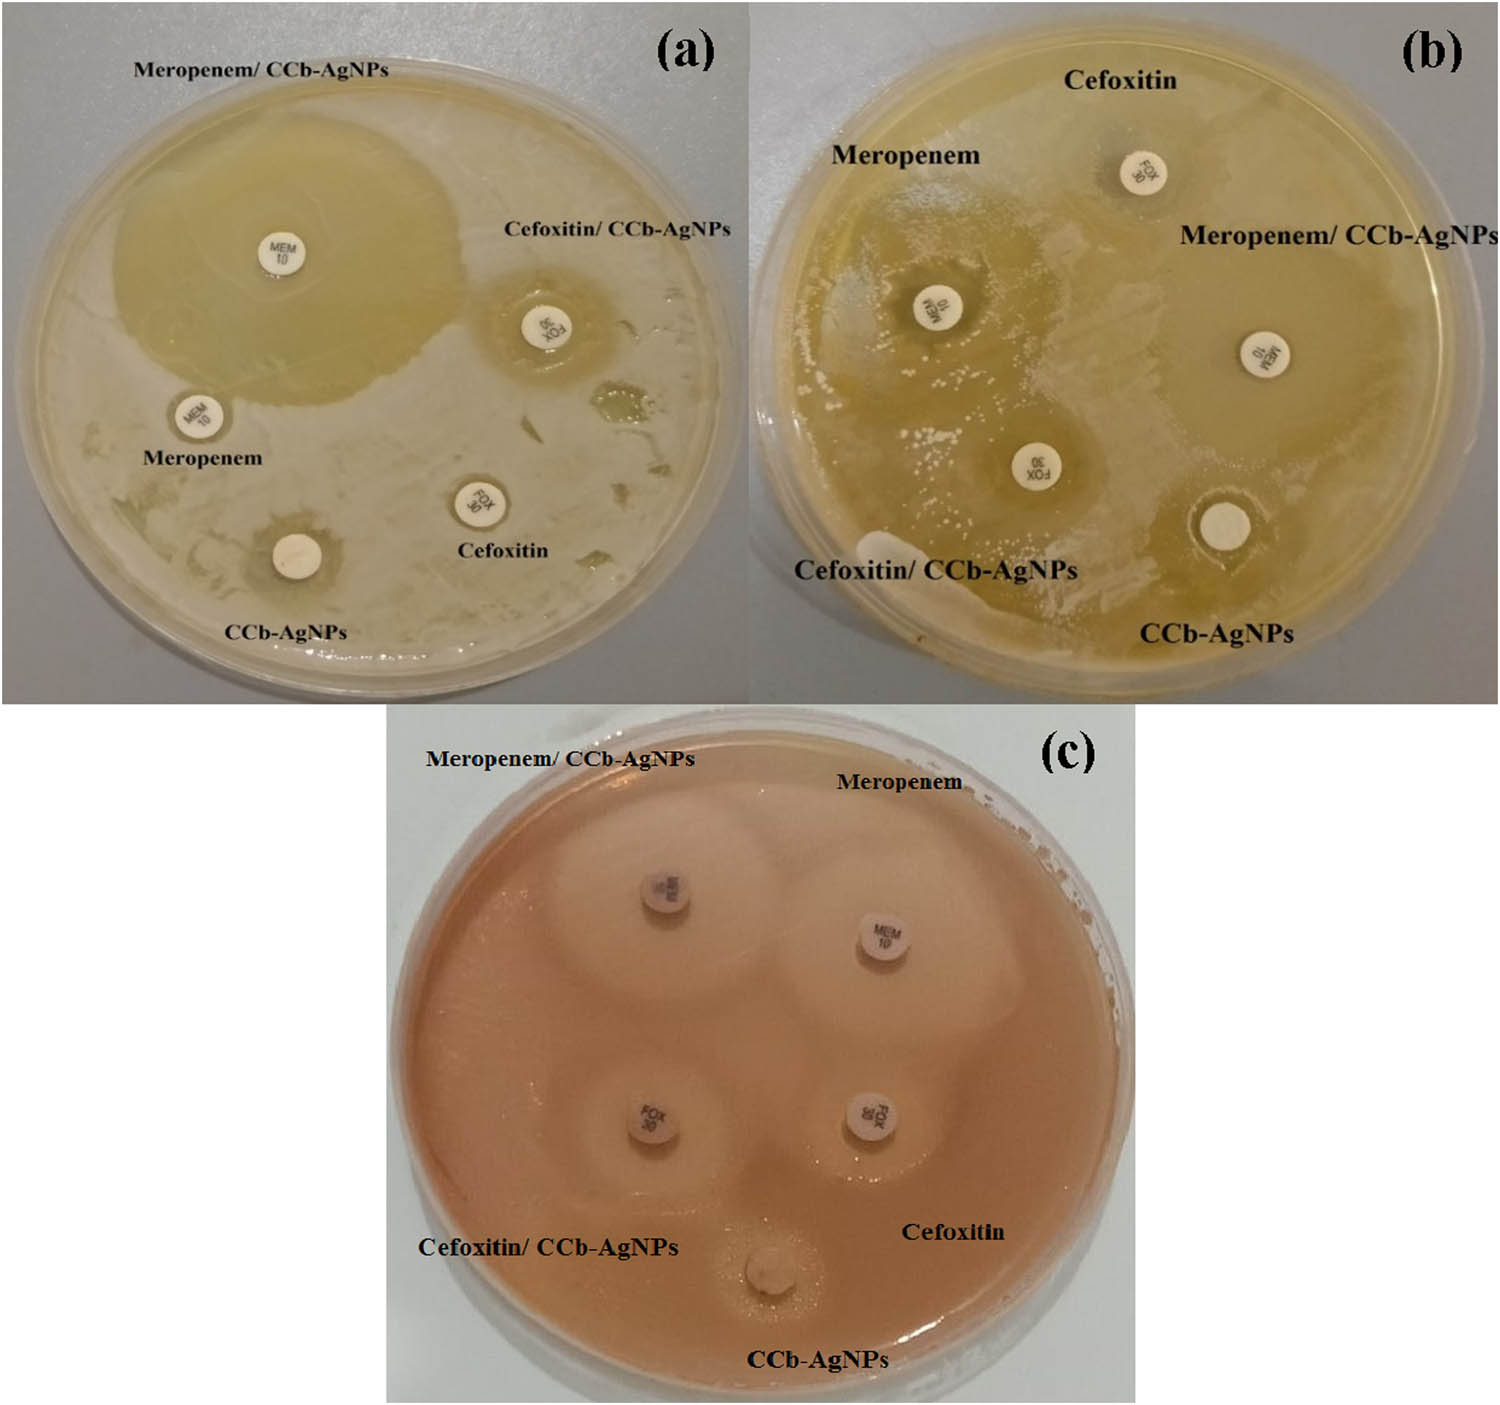

Abstract
Herein, we used the aqueous extract of Uncaria tomentosa L. barks (Cat’s claw bark [CCb]) for the biofabrication of silver nanoparticles (CCb-Ag-NPs). The effects of different parameters (Uncaria tomentosa L. aqueous extract, silver nitrate [AgNO3] ratio, temperature, and pH) on the formation of the nanoparticles were investigated using UV scan as a preliminary tool for the detection of surface plasmon resonance of CCb-Ag-NPs. The optimal ratio was 1:7 (Uncaria tomentosa L. extract: 1 mM AgNO3 solution). Fourier-transform infrared spectroscopy revealed the functional groups of both CCb extract and the CCb-Ag-NPs, whose dispersion and quasispherical morphologies were characterized using scanning electron microscopy and transmission electron microscopy. Particle sizes ranged from 19.2 to 38.5 nm. The zeta potential of CCb-Ag-NPs was −34.44 mV. According to energy-dispersive X-ray analysis, the CCb-Ag-NPs contained 28.87% silver. The formation of Ag-NPs was also confirmed by X-ray diffraction pattern analysis. Pristine CCb-Ag-NPs showed antibacterial activity against three pathogenic bacterial strains: Escherichia coli (ATCC 25922), E. coli (ATCC 8739), and Pseudomonas aeruginosa (ATCC 90274). Antibacterial activity increased significantly after loading CCb-Ag-NPs on antibiotic discs containing meropenem and cefoxitin. Low concentrations of CCb-Ag-NPs also enhanced the germination percentage, coleoptile length, and radical root length of Triticum aestivum.
1 Introduction
A major global concern regarding the use of most antibiotics is the growing resistance of bacteria to these antibiotics, which has led to substantial health consequences in recent decades [1]. Microorganism resistance, which was initially characterized by the development of treatment resistance in microorganisms, lowered therapeutic indices, toxicity, side effects, non-specific effects, and dosage issues, has been caused by the frequent use of antibiotics [2]. Better-acting antibiotics have been sought after continually during the resistance period, alongside the increase in antibiotic resistance over the past 10 years, mostly due to the common and improper use of these therapeutic medicines [3]. Silver nanoparticles (Ag-NPs) have emerged as one of the most promising materials for combating drug-resistant bacteria due to their remarkable antibacterial characteristics. In that case, nanoscience and nanotechnology are focused on the synthesis, characterization, and applications of nanostructured materials. These materials have at least one dimension that is in the nanoscale range. The ability to pattern and describe materials at the nanoscale is driving a revolution in materials science and engineering. Comparing similar materials in the bulk and nanoscales might show remarkably contradictory characteristics. The primary reason for these different properties of nanoparticles, aside from the underlying and physicochemical properties of the metals in issue, is the extreme shift in surface-to-volume ratios as we enter into the nanoscale [4,5]. Nowadays, nanoscience contributes to the production of a wide range of various synthesized metal nanoparticles (MNPs). Also, MNPs have exceptional electrical, optical, magnetic, and mechanical characteristics and are being created at a rapid pace for applications in bioengineering, information technology, energy, and the environment, as well as usage in drug delivery and bioimaging [6]. A major factor in the development of advanced nanomedicines is the successful application of various nanoparticle- and nanotechnology-based therapies against pathogenic microorganisms [7].
The noble metal silver is inert and relatively stable compared to other metals and has a highly positive electrochemical potential (0.80 V); thus, it has been interesting recently because it is well-suited for the fabrication of nanoparticles [8,9,10]. Notably, the slow leaching of Ag+ ions is harmful to pathogens but not normal cells [11,12,13]. Ag-NPs have a wide spectrum of bactericidal and fungicidal activities as well as the ability to coordinate with various ligands and macromolecules in microbial cells. Also, Ag-NPs have been widely used in the control of microbial proliferation as well as in curing wound healing due to their anti-inflammatory effects. Due to their antioxidant properties, Ag-NPs are extremely useful in the prevention and treatment of diseases [3,4,14]. As an alternative to “nanoscale antibiotics,” the term “nanobiotics” was recently introduced in medical science. It was reported that Ag-NPs have been used in conjunction with certain antibiotics, and these AgNPs have been demonstrated to kill around 650 disease-causing microorganisms without endangering human health [7]. This combination has made it possible to resolve several problems related to antibiotic-resistant microorganisms.
Ag-NPs can be fabricated physically and chemically using different techniques. Physical techniques involve elaborate procedures that have the disadvantage of a lack of size control. Chemical techniques used are sol–gel, chemical co-precipitation, and electrochemical and hydrothermal methods. These techniques have some disadvantages, such as requiring organic solvents and harsh conditions in addition to being expensive and having hazardous effects on the environment. However, the use of green synthesis techniques provides cost-effective, simple, and safe fabricated techniques. Additionally, they make use of renewable resources and non-toxic chemicals, which finally leads to a decrease in waste and pollution [15]. In the fabrication of Ag-NPs, green synthesis strategies use naturally biodegradable components, such as polysaccharides, biopolymers, vitamins, plant extracts, and microorganisms, microbial enzymes, fungi, and extract of different parts from plants [16,17]. Due to their reducing properties, such extracts can help incorporate silver ions into nanoparticles. Plant-derived biomolecules like tannins, alkaloids, and terpenoids are easy to handle and maintain while serving as reducing, capping, and stabilizing agents [18]. Recently, plant extracts from several species, such as seeds [19], leaves [20,21,22], fruits [23], bark [24,25], woodchips [26], and roots [5,27], have been investigated for their ability to generate metallic nanoparticles. However, the optimal conditions for plant-based nanoparticle synthesis remain unclear [5,28]. Ag-NPs can benefit from low toxicity and biocompatibility of plant-based synthesis that enables widespread use. Water is primarily employed as the extraction solvent when employing plant extracts to create Ag-NPs. In some cases, an ethanol or methanol solution was also used [29]. Cat’s claw is a popular name for the medicinal plant Uncaria tomentosa L., whose thorns resemble claws [30]. Cat’s claw bark (CCb) is rich in alkaloids, polyphenolics, including hydroxybenzoic acid and tannins, and flavonoids [31]. Many diseases can be treated with the inner bark of this plant, like rheumatoid arthritis, diabetes, and allergies. The anti-inflammatory and polyphenolic compounds extracted from this inner bark can also be used to prevent some cancers [32,33].
To the best of our knowledge, no studies have been published on the biological applications of nanoparticles fabricated using the CCb extract. Thus, this study focuses on the applications of Ag-NPs that are fabricated using an aqueous extract of Uncaria tomentosa L. as a reducing and stabilizing agent. The surface plasmon resonance (SPR) absorption spectra of the CCb extract and fabricated CCb-Ag-NPs under different conditions were assessed by UV–Vis spectrophotometry. The functional groups of the CCb aqueous extract and the fabricated CCb-Ag-NPs were identified using Fourier-transform infrared spectroscopy (FT-IR). The physicochemical properties such as size, shape, size distribution, and X-ray diffraction (XRD)-based composition were analyzed using scanning electron microscopy (SEM), transmission electron microscopy (TEM), XRD, energy-dispersive X-ray spectroscopy (EDS), and zeta potential analysis techniques. The important aim of this study was to investigate the antibacterial activity of meropenem/loaded CCb-Ag-NPs (MEM/CCb-Ag-NPs) and cefoxitin/loaded CCb-Ag-NPs (FOX/CCb-Ag-NPs) against three pathogenic bacterial strains: Escherichia coli (ATCC 25922), E. coli (ATCC 8739), and Pseudomonas aeruginosa (ATCC 90274). Additionally, the effect of CCb-Ag-NPs on wheat seed germination was studied. Finally, the hemolytic activity of the fabricated CCb-Ag-NPs was measured and evaluated.
2 Materials and methods
2.1 Materials
CCb was collected from Amman, Jordan. Silver nitrate (AgNO3) was purchased from Sigma-Aldrich. All aqueous solutions were prepared using double-distilled water. All reagents used were of analytical grade.
2.2 Preparation of the CCb extract
CCb was washed several times with tap water and then twice with distilled water to remove the surface impurities. It was then dried for several days at room temperature. An automatic mortar was used to grind the bark into a homogenous fine powder. The powdered CCb was sieved using a sieve of size 250 μm. The aqueous extract of CCb was prepared by mixing 5.0 g of the finely ground CCb powder with 100 mL of distilled water at 4°C for 24 h with gentle shaking. Then, the aqueous extract was separated from the residue by centrifugation at 6,000 rpm for 20 min to obtain a clear solution, which was frozen until used for the biofabrication process (Figure 1).

CCb and its powder.
2.3 Biofabrication of CCb-Ag-NPs
Ag-NPs were fabricated using the bottom-up method, as described by Zargar et al. [33], with some modifications. About 35.0 mL of 1.0 mM AgNO3 solution was added to 5.0 mL of the CCb extract solution (5%). The mixtures were stirred for 30 min at 80°C using a hot plate stirrer. The color of the reaction mixture changed to brown and gradually became darker after 24 h of storage in dark bottles, which indicated the formation of Ag-NPs. The biofabricated Ag-NPs were separated by centrifugation at 10,000 rpm for 20 min and washed twice with distilled water to remove any organic contaminants. Ag-NPs were then lyophilized using a freeze-dryer (LABCONCO, Kansas, USA). Thus, the biofabricated AgNPs were ready for characterization and further study applications (Figure 2). The effective mixture ratio was investigated by adding different volumes of 1 mM AgNO3 to 5 mL of the CCb extract to obtain a series of ratios (1:1, 1:3, 1:5, 1:7, and 1:9) (CCb extract:AgNO3 solution). The optimal temperature for the biofabrication of CCb-Ag-NPs was determined by incubating the reaction mixture at 20, 40, 60, and 80°C. The optimal reaction time was investigated by incubating the reaction mixture at 80°C for 15, 45, 60, 120, 180, and 210 min. The impact of pH on the stability of the formed CCb-Ag-NPs was investigated by adjusting the pH of the reaction mixture to pH levels 5.6, 7, 8, and 9 using 0.1 M NaOH/HCl solutions.

Schematic illustration of the biofabrication of CCb-Ag-NPs.
2.4 UV–visible spectra of CCb-Ag-NPs
The SPR absorption spectra of the CCb extract and biofabricated CCb-Ag-NPs under different conditions were obtained in the scan range of 200–800 nm using a UV–visible spectrophotometer (Shimadzu UV-1800, Japan) with a 1.0 cm quartz cell.
2.5 Characterization of CCb-Ag-NPs
The functional groups of both the CCb aqueous extract and the biofabricated CCb-Ag-NPs were identified using FT-IR (Frontier FT-IR spectrometer, Perkin-Elmer, USA) from 4,000 to 400 cm−1. The morphology of the biofabricated CCb-Ag-NPs was assessed by SEM operating at 30 kV (SEM, JEOL JSM-6510/v, Tokyo, Japan). The morphology and size of the particles of the biofabricated CCb-Ag-NPs were determined by TEM (JEOL JSM-6510/v, Tokyo, Japan) at the nanoscale. The XRD pattern of CCb-Ag-NPs was assessed with an X-ray diffractometer (PAN Analytical X-Pert PRO). The size of nanoparticles (D) was calculated according to Scherrer’s equation:
where λ is the wavelength (nm) of the X-ray, β is the full width at half-maximum, and k is a constant related to the crystallite shape (=0.9). The value of β in 2θ axis of the diffraction profile is in radians.
A field emission scanning electron microscope equipped with EDS (JEOL JSM-6510/v, Tokyo, Japan) was used to examine the shape of the CCb-Ag-NPs. The zeta potential of the biofabricated CCb-Ag-NPs supports the aspects of stabilization in the middle of the liquid when it is dispersed (Malvern Zeta size Nano-Zs90, Malvern, USA).
2.6 In vitro biological activities
2.6.1 Antibacterial activities
The disk-diffusion method was used to assess the antimicrobial activity of pristine CCb-Ag-NPs, MEM/CCb-Ag-NPs, and FOX/CCb-Ag-NPs against three pathogenic bacterial strains E. coli (ATCC 25922), E. coli (ATCC 8739), and P. aeruginosa (ATCC 90274). Inhibition zones around the disks were measured according to Wikler as an ordinary scale for bacterial growth inhibition [34]. Three tested bacterial strains were incubated at 37°C for 48 h until the colony-forming units (CFUs) reached approximately 108 CFU·mL−1 in Luria–Bertani broth media. Pure cultures of bacterial strains (100 μL) were subcultured onto a Mueller Hinton Agar plate. A filter paper (Whatman No. 3) disc with a 6 mm diameter was saturated with 50 μL of the test solution (CCb-Ag-NPs, MEM/CCb-Ag-NPs, and FOX/CCb-Ag-NPs) and transferred to the sub-cultured bacteria. Pure meropenem and cefoxitin discs (10 mg·mL−1) were used as controls, and plates were incubated at 37°C for 48 h.
2.6.2 Effect of CCb-Ag-NPs on wheat growth
Wheat seed germination was assessed as previously described [35,36] with some modifications. Triticum aestivum L. seeds were sterilized using 75% ethanol for 5 min, followed by washing with distilled water. The experiment was conducted using three replicates, and each group contained 40 seeds. Different concentrations of CCb-Ag-NPs were prepared at 10, 20, 40, 80, and 160 mg·mL−1. Seeds were soaked for 8 h at the previously mentioned concentrations of CCb-Ag-NPs, and another group was soaked in distilled water as a control. The seed germination rate was estimated after 48 and 96 h. The soaked Triticum aestivum seeds were transferred into Petri dishes containing three sheets of filter paper, and an appropriate amount of water was added every day. The incubation conditions were 20 ± 2°C, a photocycle consisting of 12 h/12 h day/night, and relative humidity of 65%. Seedling growth rates, the coleoptile length (CL), and radical root length (RRL) were estimated after 4 and 8 days.
2.6.3 Effect of CCb-Ag-NPs on erythrocyte hemolysis
The hemolytic activity of the fabricated CCb-Ag-NPs was measured using blood-contacting medical devices. Here, the n hemolytic effect of CCb-Ag-NPs was studied in the whole blood of two healthy male donors, where the hematocrit percentage was quantified as 42.6 ± 0.11% and 44.2 ± 0.18% and stabilized using potassium EDTA (10%) as an anticoagulant in a volume ratio of 10 μL EDTA to 1 mL blood. RBCs were washed three times using saline solution, and 100 μL of washed RBCs were incubated for 2 h at 37°C with 100 μL of different concentrations of CCb-Ag-NPs (5, 10, 20, 40, and 80 mg·mL−1). Blank samples were prepared using distilled water as a positive control (complete hemolytic action) and saline as a negative control (no hemolytic action). Incubated samples were centrifuged for 5 min at 2,000 rpm. The percentage of RBC hemolysis triggered by direct contact between CCb-Ag-NPs and RBCs was detected by measuring the absorbance of the supernatant at 541 nm. Hemolytic activity was calculated using the following formula:
where AS is the absorbance of the sample, AP is the absorbance of PBS (negative control), and AW is the absorbance of distilled water (positive control).
2.6.4 Statistical analysis
The mean of determinations done in triplicate is the total of all values, according to the latest release of SPSS 16. The study employed a one-way analysis of variance to statistically analyze the data. The least significant difference is determined at the P 0.05 level.
3 Results and discussion
3.1 UV–Vis spectroscopy assessment of CCb-Ag-NPs
Cat’s claw includes numerous powerful compounds, and the water-soluble mixtures present in the aqueous extract reliably stabilized the Ag-NPs and reduced metal ions. UV–Vis spectroscopy validated the creation and stability of Ag-NPs, whose dark brown color was due to the excitation of SPR and related to the size and intensity of CCb-Ag-NPs [37]. Figure 3 shows the stability of CCb-Ag-NPs at different time intervals from 0 to 210 min. The UV–Vis spectra reveal CCb-Ag-NP SPR bands centered at 416, 423, 437, 442, and 443 nm at intervals of 0, 15, 45, 60, and 120 min, respectively, and the stability of the CCb-Ag-NPs aqueous solution increased after 180 and 210 min. Intense bands were observed at 443 and 442 nm with absorbance intensities at 1.347 and 1.298, followed by broad bands at 437, 423, and 416 nm. It was reported that the UV–Vis spectra of Ag-NPs biofabricated with the Mimusops elengi L. leaf extract at 10, 30, 90, and 120 min, or 30 days were recorded at 434 nm [38]. Abo-Elmagd et al. [39] reported the highest absorption bands of the Oscillatoria gelatin-capped Ag-NPs that slightly shifted from 446 to 449 nm with increasing intensity of 0.8–1.6 by increasing the reaction time, and therefore, the NP size increased with increasing reaction time. The size, shape, and number of biofabricated Ag-NPs depend on the duration of exposure to silver ions [40]. A broad SPR band reflects the size of NPs, whereas broadband denotes the large size of NPs [41,42].

UV–Vis spectra of the CCb aqueous extract and CCb-Ag-NPs after 0, 15, 45, 60, 120, 180, and 210 min.
Different mechanisms for the green fabrication of metal NPs have been suggested by researchers. The possible mechanism for the fabrication of Ag-NPs in this study is illustrated in Scheme 1. The CCb aqueous extract contains organic phytoconstituents such as alkaloids, polyphenolics, tannins, and flavonoids, which react as biological reductants [31]. Silver ions in the salt solution accept electrons from the functional groups and reduce to silver zerovalent toms [4,6].

Possible mechanism for the formation of CCb-Ag-NPs.
3.2 Effect of ratio, temperature, and pH on the biofabrication of CCb-Ag-NPs
Ag-NPs were fabricated with the CCb extract using different ratios, and 1:5 and 1:7 ratios of CCb aqueous extract to 1 mM AgNO3 solution generated the highest SPR (Figure 4a). The 1:7 ratio was optimal for further experiments because its band was centered at a shorter wavelength compared with that of the 1:5 ratio. Previous work [43] showed that the size of the nanoparticles decreased, so the SPR shifted to shorter wavelengths. The optimal heating temperature for the biofabrication of Ag-NPs using the CCb extract was determined by UV–Vis spectroscopy. Figure 4b shows the increase in the SPR of Ag-NPs when the temperature of the mixture was raised from 20°C to 80°C for 90 min. The highest intensity was observed at 80°C, which indicates that the rate of fabrication at room temperature can be increased by increasing the temperature of the mixture. Anees Ahmad et al. [44] showed that the absorbance of Ag-NPs synthesized using the Euphorbia serpens Kunth extract increased when the temperature increased from 30°C to 60°C, though the particles became polydispersed at high temperatures. The pH of the reaction largely determines the efficiency of the reaction. Figure 4c shows the SPR of the mixture of the CCb extract and silver salt incubated at 80°C for 90 min at various pH levels (5.6, 7.0, 8.0, and 9.0). pH 9.0 maximized the fabrication of Ag-NPs with an absorption band centered at 412 nm. However, at pH 5.6, a broad band centered at 439.5 nm indicates the nonuniform particle size. Veerasamy et al. [45] claimed that more functional groups are available to bind silver under basic conditions, increasing the fabrication of Ag-NPs with smaller diameters. Other studies [25,46] also found that alkaline pH conditions are favorable for the fabrication of Ag-NPs.

UV–Vis spectra of the biofabrication of CCb-Ag-NPs at different parameters: reactant mixture (CCb extract: AgNO3) (a), temperature (b), and pH (c).
3.3 Characterization of the biofabricated CCb-Ag-NPs
3.3.1 FT-IR assessment of CCb-Ag-NPs
Table 1 and Figure 5 show the FT-IR spectra of both CCb and CCb-Ag-NPs. CCb and CCb-Ag-NPs generated 11 and 10 peaks, respectively. The broad peaks at 3,421, 2,858, 1,742, 1,618, 1,446, 1,052, and 524 cm−1 in the CCb extract spectrum shifted to 3,414, 2,854, 1,729, 1,618, 1,446, 1,063, and 519 cm−1 in the CCb-Ag-NP spectrum, respectively. Three peaks in the FT-IR spectrum of the CCb extract at 1,319, 1,263, and 835 cm−1 were absent in the CCb-Ag-NP spectrum, whereas two peaks in the CCb-Ag-NP spectrum at 1,377 and 722 cm−1 were absent in that of the CCb extract spectrum. A band at 2,924 cm−1 was found in both spectra and was attributed to the asymmetric stretching vibrations of CH and CH2. Overall, some peaks shifted to higher-frequency positions and others to lower-frequency positions; the active groups assigned to these peaks reduced the Ag ions and stabilized the CCb-Ag-NPs [47].
Assignment of the FT-IR spectra of the CCb extract and CCb-Ag-NPs
| CCb extract | CCb-Ag-NPs | Shift | Vibrational type | Reference |
|---|---|---|---|---|
| 3,421 | 3,414 | −7 | Stretching vibration of the O–H bonds | [48] |
| 2,924 | 2,924 | − | Asymmetric stretching vibrations of CH2 | [49] |
| 2,858 | 2,854 | −4 | CH2 in the aliphatic compound | [50] |
| 1,742 | 1,729 | −13 | ν(C═O) | [51] |
| 1,618 | 1,624 | +6 | Amide I | [52] |
| 1,446 | 1,459 | +13 | CC and CCH in the rings | [53] |
| 1,319 | − | − | C–H | [54] |
| − | 1,377 | − | CH3 | [55] |
| 1,263 | − | − | C–O stretching vibrations | [56] |
| 1,052 | 1,063 | +11 | C–O | [57] |
| 835 | − | − | Vibration bond of CH2 | [58] |
| − | 722 | − | CH2 | [59] |
| 524 | 519 | −5 | Peak of alkyl halide | [47] |

Comparative FT-IR spectra of the CCb extract and corresponding CCb-Ag-NPs.
3.3.2 TEM and SEM analysis
The shapes and sizes of the biofabricated CCb-Ag-NPs were distinguished using SEM and TEM. CCb-Ag-NPs were well dispersed and quasispherical with anisotropic nanostructures (Figure 6), and their sizes ranged from 19.2 to 38.5 nm and showed a good distribution with no clusters. TEM has been used previously to assess the morphology, size, and distribution of nanoparticles [60]. SEM image also shows the rough contour of the biofabricated CCb-Ag-NPs, whose well-defined distribution agreed with Rasheed et al. [61].

SEM and TEM image of biofabricated CCb-Ag-NPs.
3.3.3 Zeta potential of CCb-Ag-NPs
Zeta potential analysis was performed to measure the electrophoretic mobility of NPs and reflects the surface charge and stability of NPs [62]. Figure 7 shows the zeta potential of CCb-Ag-NPs at pH 5.6 and 25°C, where the mean value was −34.44 mV. CCb-Ag-NPs were stable due to the electrostatic repulsion [62], and a zeta potential of less than −15 mV ensures stability by creating a high-energy barrier [63]. These electrostatic repulsive forces, which are negatively charged, may also reduce the aggregation of MNPs [64]. CCb is also a reliable reducing and stabilizing agent. Abo-Elmagd et al. [65] attributed the high stability of NPs to bioorganic compounds that act as reducing and capping agents. Moreover, a Zeta sizer was used to measure the size of CCb-Ag-NPs as 40 nm.

Zeta potential analysis of biofabricated CCb-Ag-NPs.
3.3.4 EDS spectra of CCb-Ag-NPs
A large amount of silver (28.87%) was discernible at a wavelength of about 3 keV (Figure 8), confirming the presence of elementary silver at the nanoscale that could be attributed to its high SPR [66]. Due to SPR, Ag-NPs typically exhibit a prominent optical absorption peak at about 3 keV [62]. Other additional peaks were detected, such as C, O, Cl, and K, with mass% of 27.98, 36.83, 4.27, and 2.05, which indicated that biomolecules capped the biofabricated CCb-Ag-NPs.

EDS spectrum of biofabricated CCb-Ag-NPs.
3.3.5 XRD pattern of CCb-Ag-NPs
The XRD pattern of CCb-Ag-NPs is shown in Figure 9. It has been found from the XRD pattern that the maximum biofabricated phase is related to CCb-Ag-NPs, which denotes the formation of AgNPs in the sample. The diffraction lines positioned at 27°, 32°, 38°, 44°, 46°, 54°,57°, and 64° are related to the (110), (111), (200), (210), (211), (220), (220), and (310) (hkl) planes of metallic silver, respectively. According to many studies and the set (hkl) planes of the crystal, there is further indication that silver is crystallized. In Figure 9 and Table 2, red denotes Ag (87%) and blue denotes AgCl (13%), indicating the purity and stability of CCb-Ag-NPs. According to Hamouda et al. [67], the atomic spacing of protein-capped IEPS-Ag-NPs yields four noticeable peaks at 2θ values of 38.16°, 46.35°, 64.08°, and 77.71°, which matched the (111), (200), (220), and (311) (hkl) planes of the crystallographic structure (face-centered cubic). Ag-NPs biofabricated by Ulva fasciata generated five peaks at 2θ of 27°, 32°, 46°, 57°, and 76° corresponding to (111), (200), (220), (222), and (331) [68], whereas those biofabricated by Turbinaria turbinata showed visible peaks at 2θ 27.66°, 32°, 46°, 54°, 57°, 67°, 74°, and 76°, which matched the lattice planes (hkl) at (110), (111), (200), (220), (311), (222), (400), (331), and (420), confirming the crystallinity of Ag-NPs [69,70]. According to XRD, the average size ranged from 21.76 to 79.44. The major crystalline peak was investigated at 2θ (32.29°) with an intensity of 100% and a crystalline size of 37.12 nm. The size obtained by XRD was larger than that obtained by TEM and may be a personification step in the TEM procedure [71].

XRD patterns of the biofabricated CCb-Ag-NPs.
XRD data for CCb-Ag-NPs
| D (Å) | 2θ | Intensity (%) | D (nm) | hkl |
|---|---|---|---|---|
| 3.19707 | 27.884 | 45.0 | 27.11 | 110 |
| 2.76956 | 32.297 | 100 | 37.12 | 111 |
| 2.35742 | 38.144 | 77.5 | 79.44 | 200 |
| 2.04741 | 44.201 | 25.9 | 79.44 | 210 |
| 1.95968 | 46.292 | 73.1 | 34.84 | 211 |
| 1.67344 | 54.814 | 21.8 | 30.32 | 220 |
| 1.60211 | 57.476 | 19.0 | 79.44 | 220 |
| 1.44267 | 64.544 | 34.0 | 21.76 | 310 |
3.4 Biological activity
3.4.1 Antibacterial activity of CCb-Ag-NPs
Figure 10 shows the antimicrobial activity of pristine CCb-Ag-NPs, MEM/CCb-Ag-NPs, and FOX/CCb-Ag-NPs against three pathogenic bacterial strains. For E. coli (ATCC 25922), the inhibition zones of the freshly prepared CCb-Ag-NPs, FOX, FOX/CCb-Ag-NPs, MEM, and MEM/CCb-Ag-NPs were 7.6, 3.7, 10.3, 4.9, and 28.4 mm, respectively. For E. coli (ATCC 8739), the inhibition zones were 11.8, 9.6, 14.2, 18.6, and 23.3 mm for CCb-Ag-NPs, FOX, FOX/CCb-Ag-NPs, MEM, and MEM/CCb-Ag-NPs, respectively. For P. aeruginosa (ATCC 90274), the inhibition zones were 7.3, 6.8, 10.7, 16.6, and 22.1 for CCb-Ag-NPs, FOX, FOX/CCb-Ag-NPs, MEM, and MEM/CCb-Ag-NPs (Figure 11).
Antibacterial activity (zone of inhibition) of CCb-Ag-NPs against E. coli (ATCC 25922) (a), E. coli (ATCC 8739) (b), and P. aeruginosa (ATCC 90274) (c).

Antibacterial activity of CCb-Ag-NPs against E. coli (ATCC 25922), E. coli (ATCC 8739), and P. aeruginosa (ATCC 90274). Different letters have significant values.
The prevalence of antibiotic-resistant E. coli and P. aeruginosa strains is a public health problem worldwide, and their eradication has become progressively difficult as a result of their notable capacity to resist already-used antibiotics [72,73]. Ag-NPs can help combat bacterial pathogens, as Ag+ can bind to different bacterial cell components, such as the cell wall, and enable cytoplasm to flow from the injured cell wall [74]. Although the mechanisms behind the bactericidal activity of Ag-NPs or the released Ag+ ion are poorly characterized, the synthesized Ag-NPs exert bactericidal activity against several bacterial species [75]. The synthesized NPs that are partially positive can adhere to the membrane of anionic bacterial cells through electrostatic interactions, which depolarize the membrane and perturb its permeability of internal cell contents like enzymes, proteins, DNA, and metabolic components leak, resulting in bacterial cell death [76]. Some reports [77,78] attributed the bactericidal potential of Ag-NPs to their smaller size, which interacts with the bacterial cell, damages respiratory enzymes, and reduces intracellular ATP levels, and other mechanisms include silver ion stress and the generation of reactive oxygen species. Other studies [79] claim that Ag-NPs coupled with antibiotics are more effective against Gram-negative bacteria than Gram-positive ones. Our data agree with Hamouda et al. [14], who studied the synergetic bactericidal effect of both synthesized Ag-NPs alone and cefaxone-conjugated NPs against E. coli.
3.4.2 Effect of fabricated CCb-Ag-NPs on wheat germination
The effects of the biofabricated CCb-Ag-NPs on the growth of Triticum aestivum seedlings were assessed based on the parameters of germination percentage, CL (mm), and RRL (mm) (Figure 12). Different concentrations (10, 20, 40, 80, and 160 mg·mL−1) of CCb-Ag-NPs were used, and the results are shown in Figure 13(a)–(c). Low concentrations (10 and 20 mg·mL−1) of CCb-Ag-NPs enhanced the Triticum aestivum germination percentage, CL, and RRL (Figure 13). However, higher concentrations (40, 80, and 160 mg·mL−1) reduced these parameters.

Effect of different concentrations of CCb-Ag-NPs on Triticum aestivum seed germination.

Effect of different concentrations (0, 10, 20, 40, 80, and 160 mg·mL−1) of CCb-Ag-NPs on Triticum aestivum seed germination (a), CL (mm) (b), and RRL (mm) (c).
Both chemical and physical properties of the synthesized Ag-NPs, such as shape, size, concentration, and surface coatings, can detect inhibitory and stimulatory action, as well as other experimental parameters (dosage, exposure period, and plant species) that play a vital role in the germination and the subsequent growth process [36,80]. Soaking plant seeds using Ag-NPs can stimulate several chemical pathways, such as breaking of dormancy, growth inhibitory metabolite, hydrolysis or imbibition, and enzyme activation [36,81]. Previous studies [36] reported that low dosages of Ag-NPs (25–50 mg·mL−1) stimulate wheat germination and other growth parameters. AgNPs are able to increase α-amylase activity causing higher soluble sugars that support seedlings in the early growth stage, and AgNPs were also found to have a stimulation effect on the aquaporin genes in germinating seeds [82]. Previous studies [36] hypothesized that AgNPs can enhance seed germination with at least three probable mechanisms, including (i) the formation of nanopores in the seed coat, (ii) a generation of reactive oxygen species, and (iii) a nanocatalyst for improving starch-degrading enzyme activity.
3.4.3 Effect of CCb-Ag-NPs on erythrocyte hemolysis
Figures 14 and 15 represent the hemolytic activity of CCb-Ag-NPs, where their activity increased with the dose of CCb-Ag-NPs. Erythrocyte hemolysis results from the direct interaction between Ag-NPs and RBCs as nanoparticles become more ionized and release Ag+ according to the particle surface area response [83]. The distinctive structures of Ag-NPs, such as their surface area and shape, interfere with the hemolytic activity of their RBCs. Hemolysis occurs when the membrane of the RBCs is compromised, resulting in hemoglobin leakage into surrounding plasma and health risks [84]. Indeed, Ag-NPs synthesized using plant extracts were found to have a low toxic effect against erythrocytes. The hemolytic activity of AgNPs was tested and formulated for biological activities, such as antibacterial activity, to estimate its biosafety and hemocompatibility as well as to detect bioactive components in the plant extracts and clarify the interaction mechanisms of the bioactive molecules with the precursor Ag salt [85].

Hemolytic activity of different concentrations (5, 10, 20, 40, and 80 μg·mL−1) of CCb-Ag-NPs.

Percentage of hemolysis caused by CCb-Ag-NPs.
4 Conclusions
Owing to their exceptional antibacterial properties, Ag-NPs have become one of the most promising materials for fighting drug-resistant bacteria. The synthesis, characterization, and use of nanostructured materials are then the main goals of nanoscience and nanotechnology. In the current study, a simple, non-toxic, and reliable approach was used to fabricate Ag-NPs using the CCb aqueous extract (a popular name for Uncaria tomentosa L.). Different techniques have been used to characterize the fabricated CCb-Ag-NPs. The antibacterial activity, wheat seed germination, and hemolytic activity of the fabricated CCb-Ag-NPs were studied and evaluated. The findings are summarized as follows:
The results of UV–Vis spectroscopy revealed that the optimal conditions for the biofabrication of CCb-Ag-NPs were the ratio between the CCb aqueous extract to 1 mM AgNO3 solution (1:7), temperature (80°C), and pH (9.0).
FT-IR gave a detailed picture of the various active groups in the CCb aqueous extract and the fabricated CCb-Ag-NPs, indicating that the presence of these active groups plays a role in reducing Ag ions and stabilizing CCb-Ag-NPs.
SEM and TEM analysis results showed that the sizes of the CCb-Ag-NPs ranged from 19.2 to 38.5 nm, with a good distribution and no clusters.
EDS and XRD results confirmed the presence of elementary silver (28.87%) and the formation of crystalline Ag-NPs.
The stability of CCb-Ag-NPs was analyzed by zeta potential measurements. A negative zeta potential mean value of −34.44 mV proved the stability of the CCb-Ag-NPs.
In conjunction with antibiotics, CCb-Ag-NPs exerted antibacterial activity against three MEM and FOX-resistant bacterial strains. The zone of inhibition is comparatively higher in the nanoparticle conjugate with antibiotics than in the individual performances. The biofabricated CCb-Ag-NPs have a synergistic bactericidal potential (accompanied by antibiotics) and advantages as biocontrol mediators for the studied pathogenic bacteria (E. coli and P. aeruginosa) due to their stability and small size.
Low concentrations of biofabricated CCb-Ag-NPs enhanced the germination percentage, CL, and RRL of Triticum aestivum seeds, while high concentrations reduced these parameters. The results indicated that the chemical and physical characteristics of the biofabricated CCb-Ag-NPs, as well as other experimental parameters (dosage, exposure period, and plant species), play a vital role in the germination and the subsequent growth process.
CCb-Ag-NPs showed hemolytic activity, and their activity increased with increasing doses of CCb-Ag-NPs. The unique surface area and morphology of CCb-AgNP interfere with the red blood cells' ability to hemolyze.
The biofabricated CCb-AgNPs may have promising applications in the medicine, agriculture, and pharmaceutical industries.
-
Funding information: The authors state no funding involved.
-
Author contributions: Reem M. Alghanmi: conceptualization, methodology, and writing – original draft, visualization and supervision; Ragaa A. Hamouda: formal analysis, writing – original draft, visualization, and supervision; Aisha H. Al-Moubaraki: writing – review and editing; Afnan A. Allouzi: investigation, resources, and writing – original draft; Muhammad A. Abuelmagd: investigation, resources, and writing – original draft.
-
Conflict of interest: The authors state no conflict of interest.
-
Data availability statement: The datasets generated during and/or analyzed during the current study are available from the corresponding author on reasonable request.
References
[1] Banin E, Hughes D. Bacterial pathogens, antibiotics and antibiotic resistance. FEMS Microbiol Rev. 2017;14:450–2.10.1093/femsre/fux016Search in Google Scholar PubMed
[2] Wilczewska AZ, Niemirowicz K, Markiewicz KH, Car H. Nanoparticles as drug delivery systems. Pharmacol Rep. 2012;64:1020–37. 10.1016/S1734-1140(12)70901-5.Search in Google Scholar
[3] Ibraheem DR, Hussein NN, Sulaiman GM, Mohammed HA, Khan RA, Al Rugaie O. Ciprofloxacin-loaded silver nanoparticles as potent nano-antibiotics against resistant pathogenic bacteria. Nanomaterials. 2022;12:2808. 10.3390/nano12162808.Search in Google Scholar PubMed PubMed Central
[4] Varadavenkatesan T, Pai S, Vinayagam R, Selvaraj R. Characterization of silver nano-spheres synthesized using the extract of Arachis hypogaea nuts and their catalytic potential to degrade dyes. Mater Chem Phys. 2021;272:125017. 10.1016/j.matchemphys.2021.125017.Search in Google Scholar
[5] Hu D, Gao T, Kong X, Ma N, Fu J, Meng L, et al. Ginger (Zingiber officinale) extract mediated green synthesis of silver nanoparticles and evaluation of their antioxidant activity and potential catalytic reduction activities with Direct Blue 15 or Direct Orange 26. PLoS One. 2022;17:1–22. 10.1371/journal.pone.0271408.Search in Google Scholar PubMed PubMed Central
[6] Shet VB, Kumar PS, Vinayagam R, Selvaraj R, Vibha C, Rao S, et al. Cocoa pod shell mediated silver nanoparticles synthesis, characterization, and their application as nanocatalyst and antifungal agent. Appl Nanosci. 2023;13:4235–45. 10.1007/s13204-023-02873-8.Search in Google Scholar
[7] Deng H, McShan D, Zhang Y, Sinha SS, Arslan Z, Ray PC, et al. Mechanistic Study of the Synergistic Antibacterial Activity of Combined Silver Nanoparticles and Common Antibiotics. Environ Sci Technol. 2016;50:8840–8. 10.1021/acs.est.6b00998.Search in Google Scholar PubMed PubMed Central
[8] Haverkamp RG, Marshall AT. The mechanism of metal nanoparticle formation in plants: Limits on accumulation. J Nanopart Res. 2009;11:1453–63. 10.1007/s11051-008-9533-6.Search in Google Scholar
[9] Makarov VV, Makarova SS, Love AJ, Sinitsyna OV, Dudnik AO, Yaminsky IV, et al. Biosynthesis of stable iron oxide nanoparticles in aqueous extracts of hordeum vulgare and rumex acetosa plants. Langmuir. 2014;30:5982–8. 10.1021/la5011924.Search in Google Scholar PubMed
[10] Dauthal P, Mukhopadhyay M. Noble metal nanoparticles: Plant-mediated synthesis, mechanistic aspects of synthesis, and applications. Ind Eng Chem Res. 2016;55:9557–77. 10.1021/acs.iecr.6b00861.Search in Google Scholar
[11] Anees Ahmad S, Sachi Das S, Khatoon A, Tahir Ansari M, Afzal M, Saquib Hasnain M, et al. Bactericidal activity of silver nanoparticles: A mechanistic review. Mater Sci Energy Technol. 2020;3:756–69. 10.1016/j.mset.2020.09.002.Search in Google Scholar
[12] Ihtisham M, Noori A, Yadav S, Sarraf M, Kumari P, Brestic M, et al. Silver nanoparticle’s toxicological effects and phytoremediation. Nanomaterials. 2021;11:1–18. 10.3390/nano11092164.Search in Google Scholar PubMed PubMed Central
[13] Ferdous Z, Nemmar A. Health impact of silver nanoparticles: A review of the biodistribution and toxicity following various routes of exposure. Int J Mol Sci. 2020;21:1–31. 10.3390/ijms21072375.Search in Google Scholar PubMed PubMed Central
[14] Hamouda RA, Hussein MH, Abo-elmagd RA, Bawazir SS. Synthesis and biological characterization of silver nanoparticles derived from the cyanobacterium Oscillatoria limnetica. Sci Rep. 2019;9:1–17. 10.1038/s41598-019-49444-y.Search in Google Scholar PubMed PubMed Central
[15] Bhole R, Gonsalves D, Murugesan G, Narasimhan MK, Srinivasan NR, Dave N, et al. Superparamagnetic spherical magnetite nanoparticles: Synthesis, characterization and catalytic potential. Appl Nanosci. 2023;13:6003–14. 10.1007/s13204-022-02532-4.Search in Google Scholar
[16] El Shafey AM. Green synthesis of metal and metal oxide nanoparticles from plant leaf extracts and their applications: A review. Green Process Synth. 2020;9:304–39. 10.1515/gps-2020-0031.Search in Google Scholar
[17] Baeshen NA, Almulaiky YQ, Afifi M, Al-Farga A, Ali HA, Baeshen NN, et al. GC-MS analysis of bioactive compounds extracted from plant rhazya stricta using various solvents. Plants. 2023;12:1–13. 10.3390/plants12040960.Search in Google Scholar PubMed PubMed Central
[18] Roy A, Ananda Murthy HC, Ahmed HM, Islam MN, Prasad R. Phytogenic synthesis of metal/metal oxide nanoparticles for degradation of dyes. J Renew Mater. 2022;10:1911–30. 10.32604/jrm.2022.019410.Search in Google Scholar
[19] Choudhary MK, Kataria J, Sharma S. Evaluation of the kinetic and catalytic properties of biogenically synthesized silver nanoparticles. J Clean Prod. 2018;198:882–90. 10.1016/j.jclepro.2018.09.015.Search in Google Scholar
[20] Ajlouni AW, Hamdan EH, Alshalawi RAE, Shaik MR, Khan M, Kuniyil M, et al. Green synthesis of silver nanoparticles using aerial part extract of the Anthemis pseudocotula boiss. plant and their biological activity. Molecules. 2023;28:246. 10.3390/molecules28010246.Search in Google Scholar PubMed PubMed Central
[21] Khan AN, Ali Aldowairy NN, Saad Alorfi HS, Aslam M, Bawazir WAB, Hameed A, et al. Excellent antimicrobial, antioxidant, and catalytic activities of medicinal plant aqueous leaf extract derived silver nanoparticles. Processes. 2022;10:1949. 10.3390/pr10101949.Search in Google Scholar
[22] Ajay S, Panicker JS, Manjumol KA, Subramanian PP. Photocatalytic activity of biogenic silver nanoparticles synthesized using Coleus Vettiveroids. Inorg Chem Commun. 2022;144:109926.10.1016/j.inoche.2022.109926Search in Google Scholar
[23] David L, Moldovan B. Green synthesis of biogenic silver nanoparticles for efficient catalytic removal of harmful organic dyes. Nanomaterials. 2020;10:202. 10.3390/nano10020202.Search in Google Scholar PubMed PubMed Central
[24] Riaz M, Suleman A, Ahmad P, Khandaker MU, Alqahtani A, Bradley DA, et al. Biogenic synthesis of AgNPs using aqueous bark extract of aesculus indica for antioxidant and antimicrobial applications. Crystals. 2022;12:252. 10.3390/cryst12020252.Search in Google Scholar
[25] Nayak D, Ashe S, Rauta PR, Kumari M, Nayak B. Bark extract mediated green synthesis of silver nanoparticles: Evaluation of antimicrobial activity and antiproliferative response against osteosarcoma. Mater Sci Eng C. 2016;58:44–52. 10.1016/j.msec.2015.08.022.Search in Google Scholar PubMed
[26] Joe MH, Jeong HT, Lee HM, Park HJ, Kim DH, Park DH, et al. Phytosynthesis of silver and gold nanoparticles using the hot water extract of mixed woodchip powder and their antibacterial efficacy. J Nanomater. 2017;2017:1–19. 10.1155/2017/8734758.Search in Google Scholar
[27] Abd El-Aziz ARM, Gurusamy A, Alothman MR, Shehata SM, Hisham SM, Alobathani AA. Silver nanoparticles biosynthesis using Saussurea costus root aqueous extract and catalytic degradation efficacy of safranin dye. Saudi J Biol Sci. 2021;28:1093–9. 10.1016/j.sjbs.2020.11.036.Search in Google Scholar PubMed PubMed Central
[28] Kumar B. Green synthesis of gold, silver, and iron nanoparticles for the degradation of organic pollutants in wastewater. J Compos Sci. 2021;5:219. 10.3390/jcs5080219.Search in Google Scholar
[29] Bao Y, He J, Song K, Guo J, Zhou X, Liu S. Plant-extract-mediated synthesis of metal nanoparticles. J Chem. 2021;2021:1–14. 10.1155/2021/6562687.Search in Google Scholar
[30] Reinhard KH. Uncaria tomentosa (Willd.) D.C.: Cat’s claw, una de gato, or saventaro. J Altern Complement Med. 1999;5:143–51. 10.1089/acm.1999.5.143.Search in Google Scholar PubMed
[31] Elgegren M, Donayre A, Kim S, Galarreta BC, Nakamatsu J. Tridimensional Alginate Films with Cat’s Claw (Uncaria tomentosa) Extract or Aloe Vera (Aloe barbadensis) Gel for Potential Use as Wound Dressings. Proceedings. 2021;69:1–8. 10.3390/cgpm2020-07225.Search in Google Scholar
[32] Shen J, Shalom J, Cock IE. The Antiproliferative Properties of Uncaria tomentosa Willd. DC. extracts against Caco2 and HeLa Cancer Cell Lines. Pharmacogn Commun. 2018;8:8–14. 10.5530/pc.2018.1.3.Search in Google Scholar
[33] Zargar M, Hamid AA, Bakar FA, Shamsudin MN, Shameli K, Jahanshiri F, et al. Green synthesis and antibacterial effect of silver nanoparticles using Vitex negundo L. Molecules. 2011;16:6667–76. 10.3390/molecules16086667.Search in Google Scholar PubMed PubMed Central
[34] Wikler MA. Methods for dilution antimicrobial susceptibility tests for bacteria that grow aerobically. Approved standard. Clsi. 2006;26:M7–A7.Search in Google Scholar
[35] Li R, He J, Xie H, Wang W, Bose SK, Sun Y, et al. Effects of chitosan nanoparticles on seed germination and seedling growth of wheat (Triticum aestivum L.). Int J Biol Macromol. 2019;126:91–100. 10.1016/j.ijbiomac.2018.12.118.Search in Google Scholar PubMed
[36] Singh Y, Kaushal S, Sodhi RS. Biogenic synthesis of silver nanoparticles using cyanobacterium: Leptolyngbya sp. WUC 59 cell-free extract and their effects on bacterial growth and seed germination. Nanoscale Adv. 2020;2:3972–82. 10.1039/d0na00357c.Search in Google Scholar PubMed PubMed Central
[37] Mulvaney P. Surface plasmon spectroscopy of nanosized metal particles. Langmuir. 1996;12:788–800. 10.1021/la9502711.Search in Google Scholar
[38] Prakash P, Gnanaprakasam P, Emmanuel R, Arokiyaraj S, Saravanan M. Green synthesis of silver nanoparticles from leaf extract of Mimusops elengi, Linn. for enhanced antibacterial activity against multi drug resistant clinical isolates. Colloids Surf B Biointerfaces. 2013;108:255–9. 10.1016/j.colsurfb.2013.03.017.Search in Google Scholar PubMed
[39] Abo-Elmagd RA, Hamouda RA, Hussein MH. Phycotoxicity and catalytic reduction activity of green synthesized Oscillatoria gelatin-capped silver nanoparticles. Sci Rep. 2022;12:20378. 10.1038/s41598-022-22976-6.Search in Google Scholar PubMed PubMed Central
[40] Lowry OH, Rosebrough NJ, Farr AL, Randall RJ. Protein measurement with the Folin phenol reagent. J Biol Chem. 1951;193:265–75. 10.1016/s0021-9258(19)52451-6.Search in Google Scholar
[41] Govindaraju K, Kiruthiga V, Kumar VG, Singaravelu G. Extracellular synthesis of silver nanoparticles by a marine alga, Sargassum wightii grevilli and their Antibacterial effects. J Nanosci Nanotechnol. 2009;9:5497–501. 10.1166/jnn.2009.1199.Search in Google Scholar PubMed
[42] Jena J, Pradhan N, Prasad Dash B, Behari Sukla L. kumar Panda Affiliations P. Biosynthesis and characterization of silver nanoparticles using microalga Chlorococcum humicola and its antibacterial activity. Int J Nanomater Biostruct. 2013;3:1–8.Search in Google Scholar
[43] Ider M, Abderrafi K, Eddahbi A, Ouaskit S, Kassiba A. Silver metallic nanoparticles with surface plasmon resonance: synthesis and characterizations. J Clust Sci. 2017;28:1051–69. 10.1007/s10876-016-1080-1.Search in Google Scholar
[44] Ahmad N, Fozia, Jabeen M, Haq ZU, Ahmad I, Wahab A, et al. Green fabrication of silver nanoparticles using euphorbia serpens kunth aqueous extract, their characterization, and investigation of its in vitro antioxidative, antimicrobial, insecticidal, and cytotoxic activities. Biomed Res Int. 2022;2022:1–11. 10.1155/2022/5562849.Search in Google Scholar PubMed PubMed Central
[45] Veerasamy R, Xin TZ, Gunasagaran S, Xiang TFW, Yang EFC, Jeyakumar N, et al. Biosynthesis of silver nanoparticles using mangosteen leaf extract and evaluation of their antimicrobial activities. J Saudi Chem Soc. 2011;15:113–20.10.1016/j.jscs.2010.06.004Search in Google Scholar
[46] Andreescu D, Eastman C, Balantrapu K, Goia DV. A simple route for manufacturing highly dispersed silver nanoparticles. J Mater Res. 2007;22:2488–96. 10.1557/jmr.2007.0308.Search in Google Scholar
[47] Jaast S, Grewal A. Green synthesis of silver nanoparticles, characterization and evaluation of their photocatalytic dye degradation activity. Curr Res Green Sustain Chem. 2021;4:100195. 10.1016/j.crgsc.2021.100195.Search in Google Scholar
[48] Rubio F, Gonçalves AC, Meneghel AP, Teixeira Tarley CR, Schwantes D, Coelho GF. Removal of cadmium from water using by-product Crambe abyssinica Hochst seeds as biosorbent material. Water Sci Technol. 2013;68:227–33. 10.2166/wst.2013.233.Search in Google Scholar PubMed
[49] Portaccio M, Errico S, Chioccarelli T, Cobellis G, Lepore M. Fourier-Transform Infrared Microspectroscopy (FT-IR) study on caput and cauda mouse spermatozoa. Multidiscip Digit Publ Inst Proc. 2019;42:19. 10.3390/ecsa-6-06537.Search in Google Scholar
[50] Sukprasert J, Thumanu K, Phung-On I, Jirarungsatean C, Erickson LE, Tuitemwong P, et al. Synchrotron FTIR light reveals signal changes of biofunctionalized magnetic nanoparticle attachment on salmonella sp. J Nanomater. 2020;2020:1–12. 10.1155/2020/6149713.Search in Google Scholar
[51] Kemel K, Baillet-Guffroy A, Faivre V, Laugel C. ATR-FTIR characterization of janus nanoparticles—Part II: follow-up skin application. J Pharm Sci. 2019;108:3366–71. 10.1016/j.xphs.2019.06.018.Search in Google Scholar PubMed
[52] Topală CM, Tătaru LD, Ducu C. ATR-FTIR spectra fingerprinting of medicinal herbs extracts prepared using microwave extraction. Arab J Med Aromat. Plants. 2017;3:1–9.Search in Google Scholar
[53] Ullah R, Ahmad I, Zheng Y. Fourier Transform infrared Spectrosc “bisphenol A”. J Spectrosc. 2016;2016:1–5.10.1155/2016/2073613Search in Google Scholar
[54] Kwon SM, Jang JH, Lee SH, Park SB, Kim NH. Change of heating value, pH and FT-IR spectra of charcoal at different carbonization temperatures. J Korean Wood Sci Technol. 2013;41:440–6. 10.5658/WOOD.2013.41.5.440.Search in Google Scholar
[55] Pennington BD, Ryntz RA, Urban MW. Stratification in thermoplastic olefins (TPO); Photoacoustic FT-IR depth profiling studies. Polymer (Guildf). 1999;40:4795–803. 10.1016/S0032-3861(98)00714-9.Search in Google Scholar
[56] Altameme HJ, Hameed IH, Abu-Serag NA. Analysis of bioactive phytochemical compounds of two medicinal plants, equisetum arvense and alchemila valgaris seeds using gas chromatography-mass spectrometry and fourier-transform infrared spectroscopy. Malays Appl Biol. 2015;44:47–58.Search in Google Scholar
[57] Cintrón MS, Hinchliffe DJ. FT-IR examination of the development of secondary cell wall in cotton fibers. Fibers. 2015;3:30–40. 10.3390/fib3010030.Search in Google Scholar
[58] Ahmed H. Spectroscopic characterization of leukemia samples using laser raman and fourier transform infrared spectroscopy. Doctoral dissertation. Sudan Univesity of Science and Technology; 2011.Search in Google Scholar
[59] Poiana MA, Alexa E, Munteanu MF, Gligor R, Moigradean D, Mateescu C. Use of ATR-FTIR spectroscopy to detect the changes in extra virgin olive oil by adulteration with soybean oil and high temperature heat treatment. Open Chem. 2015;13:689–98. 10.1515/chem-2015-0110.Search in Google Scholar
[60] Khatami M, Sharifi I, Nobre MAL, Zafarnia N, Aflatoonian MR. Waste-grass-mediated green synthesis of silver nanoparticles and evaluation of their anticancer, antifungal and antibacterial activity. Green Chem Lett Rev. 2018;11:125–34. 10.1080/17518253.2018.1444797.Search in Google Scholar
[61] Rasheed T, Bilal M, Li C, Nabeel F, Khalid M, Iqbal HMN. Catalytic potential of bio-synthesized silver nanoparticles using Convolvulus arvensis extract for the degradation of environmental pollutants. J Photochem Photobiol B Biol. 2018;181:44–52. 10.1016/j.jphotobiol.2018.02.024.Search in Google Scholar PubMed
[62] Baharara J, Namvar F, Ramezani T, Hosseini N, Mohamad R. Green synthesis of silver nanoparticles using achillea biebersteinii flower extract and its anti-angiogenic properties in the rat aortic ring model. Molecules. 2014;19:4624–34. 10.3390/molecules19044624.Search in Google Scholar PubMed PubMed Central
[63] Sankar R, Karthik A, Prabu A, Karthik S, Shivashangari KS, Ravikumar V. Origanum vulgare mediated biosynthesis of silver nanoparticles for its antibacterial and anticancer activity. Colloids Surf B Biointerfaces. 2013;108:80–4. 10.1016/j.colsurfb.2013.02.033.Search in Google Scholar PubMed
[64] Suriyakalaa U, Antony JJ, Suganya S, Siva D, Sukirtha R, Kamalakkannan S, et al. Hepatocurative activity of biosynthesized silver nanoparticles fabricated using Andrographis paniculata. Colloids Surf B Biointerfaces. 2013;102:189–94. 10.1016/j.colsurfb.2012.06.039.Search in Google Scholar PubMed
[65] Abo-Elmagd RA, Hussein MH, Hamouda RA, Shalan AE, Abdelrazak A. Statistical optimization of photo-induced biofabrication of silver nanoparticles using the cell extract of: Oscillatoria limnetica: insight on characterization and antioxidant potentiality. RSC Adv. 2020;10:44232–46. 10.1039/d0ra08206f.Search in Google Scholar PubMed PubMed Central
[66] Jain N, Bhargava A, Rathi M, Dilip RV, Panwar J. Removal of protein capping enhances the antibacterial efficiency of biosynthesized silver nanoparticles. PLoS One. 2015;10:0134337. 10.1371/journal.pone.0134337.Search in Google Scholar PubMed PubMed Central
[67] Hamouda RA, Hussein MH, Elhadary AMA, Abuelmagd MA. Extruded polysaccharide/protein matrix from Arthrospira platensis cultures mediated silver nanoparticles biosynthesis and capping. Appl Nanosci. 2020;10:3839–55. 10.1007/s13204-020-01490-z.Search in Google Scholar
[68] Hamouda RA, Yousuf WE, Abdeen EE, Mohamed A. Biological and Chemical Synthesis of Silver Nanoparticles: Characterization, MIC and Antibacterial Activity against Pathogenic Bacteria. J Chem Pharm Res. 2019;11:1–12.Search in Google Scholar
[69] Abdellatif KF, Hamouda RA, El-Ansary MSM. Green nanoparticles engineering on root-knot nematode infecting eggplants and their effect on plant dna modification. Iran J Biotechnol. 2016;14:250–9. 10.15171/ijb.1309.Search in Google Scholar PubMed PubMed Central
[70] El Bialy BE, Hamouda RA, Khalifa KS, Hamza HA. Cytotoxic effect of biosynthesized silver nanoparticles on Ehrlich ascites tumor cells in mice. Int J Pharmacol. 2017;13:134–44.10.3923/ijp.2017.134.144Search in Google Scholar
[71] Hamouda RA, Abd El-Mongy M, Eid KF. Comparative study between two red algae for biosynthesis silver nanoparticles capping by SDS: Insights of characterization and antibacterial activity. Microb Pathog. 2019;129:224–32. 10.3390/molecules27051602.Search in Google Scholar PubMed PubMed Central
[72] Pang Z, Raudonis R, Glick BR, Lin TJ, Cheng Z. Antibiotic resistance in Pseudomonas aeruginosa: mechanisms and alternative therapeutic strategies. Biotechnol Adv. 2019;37:177–92. 10.1016/j.biotechadv.2018.11.013.Search in Google Scholar PubMed
[73] Pormohammad A, Nasiri MJ, Azimi T. Prevalence of antibiotic resistance in escherichia coli strains simultaneously isolated from humans, animals, food, and the environment: A systematic review and meta-analysis. Infect Drug Resist. 2019;12:1181–97. 10.2147/IDR.S201324.Search in Google Scholar PubMed PubMed Central
[74] Sondi I, Salopek-Sondi B. Silver nanoparticles as antimicrobial agent: A case study on E. coli as a model for Gram-negative bacteria. J Colloid Interface Sci. 2004;275:177–82. 10.1016/j.jcis.2004.02.012.Search in Google Scholar PubMed
[75] Ipe DS, Kumar PTS, Love RM, Hamlet SM. Silver nanoparticles at biocompatible dosage synergistically increases bacterial susceptibility to antibiotics. Front Microbiol. 2020;11:1–11. 10.3389/fmicb.2020.01074.Search in Google Scholar PubMed PubMed Central
[76] Ali MA, Ahmed T, Wu W, Hossain A, Hafeez R, Masum MMI, et al. Advancements in plant and microbe-based synthesis of metallic nanoparticles and their antimicrobial activity against plant pathogens. Nanomaterials. 2020;10:1–24. 10.3390/nano10061146.Search in Google Scholar PubMed PubMed Central
[77] Das CGA, Kumar VG, Dhas TS, Karthick V, Govindaraju K, Joselin JM, et al. Antibacterial activity of silver nanoparticles (biosynthesis): A short review on recent advances. Biocatal Agric Biotechnol. 2020;27:101593. 10.1016/j.bcab.2020.101593.Search in Google Scholar
[78] Vanlalveni C, Lallianrawna S, Biswas A, Selvaraj M, Changmai B, Rokhum SL. Correction: green synthesis of silver nanoparticles using plant extracts and their antimicrobial activities: A review of recent literature. RSC Adv. 2022;12:16093.10.1039/D2RA90055FSearch in Google Scholar PubMed PubMed Central
[79] Perveen S, Safdar N, Chaudhry GeS, Yasmin A. Antibacterial evaluation of silver nanoparticles synthesized from lychee peel: individual versus antibiotic conjugated effects. World J Microbiol Biotechnol. 2018;34:1–12. 10.1007/s11274-018-2500-1.Search in Google Scholar PubMed
[80] Cvjetko P, Milošić A, Domijan AM, Vinković Vrček I, Tolić S, Peharec Štefanić P, et al. Toxicity of silver ions and differently coated silver nanoparticles in Allium cepa roots. Ecotoxicol Environ Saf. 2017;137:18–28. 10.1016/j.ecoenv.2016.11.009.Search in Google Scholar PubMed
[81] Yan A, Chen Z. Impacts of silver nanoparticles on plants: A focus on the phytotoxicity and underlying mechanism. Int J Mol Sci. 2019;20:1–21. 10.3390/ijms20051003.Search in Google Scholar PubMed PubMed Central
[82] Smirnov O, Kalynovskyi V, Yumyna Y, Zelena P, Levenets T, Kovalenko M, et al. Potency of phytosynthesized silver nanoparticles from Lathraea squamaria as anticandidal agent and wheat seeds germination enhancer. Biologia (Bratisl). 2022;77:2715–24. 10.1007/s11756-022-01117-4.Search in Google Scholar PubMed PubMed Central
[83] Lansdown ABG. A pharmacological and toxicological profile of silver as an antimicrobial agent in medical devices. Adv Pharmacol Sci. 2010;2010:1–16. 10.1155/2010/910686.Search in Google Scholar PubMed PubMed Central
[84] Choi J, Reipa V, Hitchins VM, Goering PL, Malinauskas RA. Physicochemical characterization and in vitro hemolysis evaluation of silver nanoparticles. Toxicol Sci. 2011;123:133–43. 10.1093/toxsci/kfr149.Search in Google Scholar PubMed
[85] Liaqat N, Jahan N, Khalil-ur-Rahman, Anwar T, Qureshi H. Green synthesized silver nanoparticles: Optimization, characterization, antimicrobial activity, and cytotoxicity study by hemolysis assay. Front Chem. 2022;10:952006. 10.3389/fchem.2022.952006.Search in Google Scholar PubMed PubMed Central
© 2024 the author(s), published by De Gruyter
This work is licensed under the Creative Commons Attribution 4.0 International License.
Articles in the same Issue
- Research Articles
- Green polymer electrolyte and activated charcoal-based supercapacitor for energy harvesting application: Electrochemical characteristics
- Research on the adsorption of Co2+ ions using halloysite clay and the ability to recover them by electrodeposition method
- Simultaneous estimation of ibuprofen, caffeine, and paracetamol in commercial products using a green reverse-phase HPTLC method
- Isolation, screening and optimization of alkaliphilic cellulolytic fungi for production of cellulase
- Functionalized gold nanoparticles coated with bacterial alginate and their antibacterial and anticancer activities
- Comparative analysis of bio-based amino acid surfactants obtained via Diels–Alder reaction of cyclic anhydrides
- Biosynthesis of silver nanoparticles on yellow phosphorus slag and its application in organic coatings
- Exploring antioxidant potential and phenolic compound extraction from Vitis vinifera L. using ultrasound-assisted extraction
- Manganese and copper-coated nickel oxide nanoparticles synthesized from Carica papaya leaf extract induce antimicrobial activity and breast cancer cell death by triggering mitochondrial caspases and p53
- Insight into heating method and Mozafari method as green processing techniques for the synthesis of micro- and nano-drug carriers
- Silicotungstic acid supported on Bi-based MOF-derived metal oxide for photodegradation of organic dyes
- Synthesis and characterization of capsaicin nanoparticles: An attempt to enhance its bioavailability and pharmacological actions
- Synthesis of Lawsonia inermis-encased silver–copper bimetallic nanoparticles with antioxidant, antibacterial, and cytotoxic activity
- Facile, polyherbal drug-mediated green synthesis of CuO nanoparticles and their potent biological applications
- Zinc oxide-manganese oxide/carboxymethyl cellulose-folic acid-sesamol hybrid nanomaterials: A molecularly targeted strategy for advanced triple-negative breast cancer therapy
- Exploring the antimicrobial potential of biogenically synthesized graphene oxide nanoparticles against targeted bacterial and fungal pathogens
- Biofabrication of silver nanoparticles using Uncaria tomentosa L.: Insight into characterization, antibacterial activities combined with antibiotics, and effect on Triticum aestivum germination
- Membrane distillation of synthetic urine for use in space structural habitat systems
- Investigation on mechanical properties of the green synthesis bamboo fiber/eggshell/coconut shell powder-based hybrid biocomposites under NaOH conditions
- Green synthesis of magnesium oxide nanoparticles using endophytic fungal strain to improve the growth, metabolic activities, yield traits, and phenolic compounds content of Nigella sativa L.
- Estimation of greenhouse gas emissions from rice and annual upland crops in Red River Delta of Vietnam using the denitrification–decomposition model
- Synthesis of humic acid with the obtaining of potassium humate based on coal waste from the Lenger deposit, Kazakhstan
- Ascorbic acid-mediated selenium nanoparticles as potential antihyperuricemic, antioxidant, anticoagulant, and thrombolytic agents
- Green synthesis of silver nanoparticles using Illicium verum extract: Optimization and characterization for biomedical applications
- Antibacterial and dynamical behaviour of silicon nanoparticles influenced sustainable waste flax fibre-reinforced epoxy composite for biomedical application
- Optimising coagulation/flocculation using response surface methodology and application of floc in biofertilisation
- Green synthesis and multifaceted characterization of iron oxide nanoparticles derived from Senna bicapsularis for enhanced in vitro and in vivo biological investigation
- Potent antibacterial nanocomposites from okra mucilage/chitosan/silver nanoparticles for multidrug-resistant Salmonella Typhimurium eradication
- Trachyspermum copticum aqueous seed extract-derived silver nanoparticles: Exploration of their structural characterization and comparative antibacterial performance against gram-positive and gram-negative bacteria
- Microwave-assisted ultrafine silver nanoparticle synthesis using Mitragyna speciosa for antimalarial applications
- Green synthesis and characterisation of spherical structure Ag/Fe2O3/TiO2 nanocomposite using acacia in the presence of neem and tulsi oils
- Green quantitative methods for linagliptin and empagliflozin in dosage forms
- Enhancement efficacy of omeprazole by conjugation with silver nanoparticles as a urease inhibitor
- Residual, sequential extraction, and ecological risk assessment of some metals in ash from municipal solid waste incineration, Vietnam
- Green synthesis of ZnO nanoparticles using the mangosteen (Garcinia mangostana L.) leaf extract: Comparative preliminary in vitro antibacterial study
- Simultaneous determination of lesinurad and febuxostat in commercial fixed-dose combinations using a greener normal-phase HPTLC method
- A greener RP-HPLC method for quaternary estimation of caffeine, paracetamol, levocetirizine, and phenylephrine acquiring AQbD with stability studies
- Optimization of biomass durian peel as a heterogeneous catalyst in biodiesel production using microwave irradiation
- Thermal treatment impact on the evolution of active phases in layered double hydroxide-based ZnCr photocatalysts: Photodegradation and antibacterial performance
- Preparation of silymarin-loaded zein polysaccharide core–shell nanostructures and evaluation of their biological potentials
- Preparation and characterization of composite-modified PA6 fiber for spectral heating and heat storage applications
- Preparation and electrocatalytic oxygen evolution of bimetallic phosphates (NiFe)2P/NF
- Rod-shaped Mo(vi) trichalcogenide–Mo(vi) oxide decorated on poly(1-H pyrrole) as a promising nanocomposite photoelectrode for green hydrogen generation from sewage water with high efficiency
- Green synthesis and studies on citrus medica leaf extract-mediated Au–ZnO nanocomposites: A sustainable approach for efficient photocatalytic degradation of rhodamine B dye in aqueous media
- Cellulosic materials for the removal of ciprofloxacin from aqueous environments
- The analytical assessment of metal contamination in industrial soils of Saudi Arabia using the inductively coupled plasma technology
- The effect of modified oily sludge on the slurry ability and combustion performance of coal water slurry
- Eggshell waste transformation to calcium chloride anhydride as food-grade additive and eggshell membranes as enzyme immobilization carrier
- Synthesis of EPAN and applications in the encapsulation of potassium humate
- Biosynthesis and characterization of silver nanoparticles from Cedrela toona leaf extracts: An exploration into their antibacterial, anticancer, and antioxidant potential
- Enhancing mechanical and rheological properties of HDPE films through annealing for eco-friendly agricultural applications
- Immobilisation of catalase purified from mushroom (Hydnum repandum) onto glutaraldehyde-activated chitosan and characterisation: Its application for the removal of hydrogen peroxide from artificial wastewater
- Sodium titanium oxide/zinc oxide (STO/ZnO) photocomposites for efficient dye degradation applications
- Effect of ex situ, eco-friendly ZnONPs incorporating green synthesised Moringa oleifera leaf extract in enhancing biochemical and molecular aspects of Vicia faba L. under salt stress
- Biosynthesis and characterization of selenium and silver nanoparticles using Trichoderma viride filtrate and their impact on Culex pipiens
- Photocatalytic degradation of organic dyes and biological potentials of biogenic zinc oxide nanoparticles synthesized using the polar extract of Cyperus scariosus R.Br. (Cyperaceae)
- Assessment of antiproliferative activity of green-synthesized nickel oxide nanoparticles against glioblastoma cells using Terminalia chebula
- Chlorine-free synthesis of phosphinic derivatives by change in the P-function
- Anticancer, antioxidant, and antimicrobial activities of nanoemulsions based on water-in-olive oil and loaded on biogenic silver nanoparticles
- Study and mechanism of formation of phosphorus production waste in Kazakhstan
- Synthesis and stabilization of anatase form of biomimetic TiO2 nanoparticles for enhancing anti-tumor potential
- Microwave-supported one-pot reaction for the synthesis of 5-alkyl/arylidene-2-(morpholin/thiomorpholin-4-yl)-1,3-thiazol-4(5H)-one derivatives over MgO solid base
- Screening the phytochemicals in Perilla leaves and phytosynthesis of bioactive silver nanoparticles for potential antioxidant and wound-healing application
- Graphene oxide/chitosan/manganese/folic acid-brucine functionalized nanocomposites show anticancer activity against liver cancer cells
- Nature of serpentinite interactions with low-concentration sulfuric acid solutions
- Multi-objective statistical optimisation utilising response surface methodology to predict engine performance using biofuels from waste plastic oil in CRDi engines
- Microwave-assisted extraction of acetosolv lignin from sugarcane bagasse and electrospinning of lignin/PEO nanofibres for carbon fibre production
- Biosynthesis, characterization, and investigation of cytotoxic activities of selenium nanoparticles utilizing Limosilactobacillus fermentum
- Highly photocatalytic materials based on the decoration of poly(O-chloroaniline) with molybdenum trichalcogenide oxide for green hydrogen generation from Red Sea water
- Highly efficient oil–water separation using superhydrophobic cellulose aerogels derived from corn straw
- Beta-cyclodextrin–Phyllanthus emblica emulsion for zinc oxide nanoparticles: Characteristics and photocatalysis
- Assessment of antimicrobial activity and methyl orange dye removal by Klebsiella pneumoniae-mediated silver nanoparticles
- Influential eradication of resistant Salmonella Typhimurium using bioactive nanocomposites from chitosan and radish seed-synthesized nanoselenium
- Antimicrobial activities and neuroprotective potential for Alzheimer’s disease of pure, Mn, Co, and Al-doped ZnO ultra-small nanoparticles
- Green synthesis of silver nanoparticles from Bauhinia variegata and their biological applications
- Synthesis and optimization of long-chain fatty acids via the oxidation of long-chain fatty alcohols
- Eminent Red Sea water hydrogen generation via a Pb(ii)-iodide/poly(1H-pyrrole) nanocomposite photocathode
- Green synthesis and effective genistein production by fungal β-glucosidase immobilized on Al2O3 nanocrystals synthesized in Cajanus cajan L. (Millsp.) leaf extracts
- Green stability-indicating RP-HPTLC technique for determining croconazole hydrochloride
- Green synthesis of La2O3–LaPO4 nanocomposites using Charybdis natator for DNA binding, cytotoxic, catalytic, and luminescence applications
- Eco-friendly drugs induce cellular changes in colistin-resistant bacteria
- Tangerine fruit peel extract mediated biogenic synthesized silver nanoparticles and their potential antimicrobial, antioxidant, and cytotoxic assessments
- Green synthesis on performance characteristics of a direct injection diesel engine using sandbox seed oil
- A highly sensitive β-AKBA-Ag-based fluorescent “turn off” chemosensor for rapid detection of abamectin in tomatoes
- Green synthesis and physical characterization of zinc oxide nanoparticles (ZnO NPs) derived from the methanol extract of Euphorbia dracunculoides Lam. (Euphorbiaceae) with enhanced biosafe applications
- Detection of morphine and data processing using surface plasmon resonance imaging sensor
- Effects of nanoparticles on the anaerobic digestion properties of sulfamethoxazole-containing chicken manure and analysis of bio-enzymes
- Bromic acid-thiourea synergistic leaching of sulfide gold ore
- Green chemistry approach to synthesize titanium dioxide nanoparticles using Fagonia Cretica extract, novel strategy for developing antimicrobial and antidiabetic therapies
- Green synthesis and effective utilization of biogenic Al2O3-nanocoupled fungal lipase in the resolution of active homochiral 2-octanol and its immobilization via aluminium oxide nanoparticles
- Eco-friendly RP-HPLC approach for simultaneously estimating the promising combination of pentoxifylline and simvastatin in therapeutic potential for breast cancer: Appraisal of greenness, whiteness, and Box–Behnken design
- Use of a humidity adsorbent derived from cockleshell waste in Thai fried fish crackers (Keropok)
- One-pot green synthesis, biological evaluation, and in silico study of pyrazole derivatives obtained from chalcones
- Bio-sorption of methylene blue and production of biofuel by brown alga Cystoseira sp. collected from Neom region, Kingdom of Saudi Arabia
- Synthesis of motexafin gadolinium: A promising radiosensitizer and imaging agent for cancer therapy
- The impact of varying sizes of silver nanoparticles on the induction of cellular damage in Klebsiella pneumoniae involving diverse mechanisms
- Microwave-assisted green synthesis, characterization, and in vitro antibacterial activity of NiO nanoparticles obtained from lemon peel extract
- Rhus microphylla-mediated biosynthesis of copper oxide nanoparticles for enhanced antibacterial and antibiofilm efficacy
- Harnessing trichalcogenide–molybdenum(vi) sulfide and molybdenum(vi) oxide within poly(1-amino-2-mercaptobenzene) frameworks as a photocathode for sustainable green hydrogen production from seawater without sacrificial agents
- Magnetically recyclable Fe3O4@SiO2 supported phosphonium ionic liquids for efficient and sustainable transformation of CO2 into oxazolidinones
- A comparative study of Fagonia arabica fabricated silver sulfide nanoparticles (Ag2S) and silver nanoparticles (AgNPs) with distinct antimicrobial, anticancer, and antioxidant properties
- Visible light photocatalytic degradation and biological activities of Aegle marmelos-mediated cerium oxide nanoparticles
- Physical intrinsic characteristics of spheroidal particles in coal gasification fine slag
- Exploring the effect of tea dust magnetic biochar on agricultural crops grown in polycyclic aromatic hydrocarbon contaminated soil
- Crosslinked chitosan-modified ultrafiltration membranes for efficient surface water treatment and enhanced anti-fouling performances
- Study on adsorption characteristics of biochars and their modified biochars for removal of organic dyes from aqueous solution
- Zein polymer nanocarrier for Ocimum basilicum var. purpurascens extract: Potential biomedical use
- Green synthesis, characterization, and in vitro and in vivo biological screening of iron oxide nanoparticles (Fe3O4) generated with hydroalcoholic extract of aerial parts of Euphorbia milii
- Novel microwave-based green approach for the synthesis of dual-loaded cyclodextrin nanosponges: Characterization, pharmacodynamics, and pharmacokinetics evaluation
- Bi2O3–BiOCl/poly-m-methyl aniline nanocomposite thin film for broad-spectrum light-sensing
- Green synthesis and characterization of CuO/ZnO nanocomposite using Musa acuminata leaf extract for cytotoxic studies on colorectal cancer cells (HCC2998)
- Review Articles
- Materials-based drug delivery approaches: Recent advances and future perspectives
- A review of thermal treatment for bamboo and its composites
- An overview of the role of nanoherbicides in tackling challenges of weed management in wheat: A novel approach
- An updated review on carbon nanomaterials: Types, synthesis, functionalization and applications, degradation and toxicity
- Special Issue: Emerging green nanomaterials for sustainable waste management and biomedical applications
- Green synthesis of silver nanoparticles using mature-pseudostem extracts of Alpinia nigra and their bioactivities
- Special Issue: New insights into nanopythotechnology: current trends and future prospects
- Green synthesis of FeO nanoparticles from coffee and its application for antibacterial, antifungal, and anti-oxidation activity
- Dye degradation activity of biogenically synthesized Cu/Fe/Ag trimetallic nanoparticles
- Special Issue: Composites and green composites
- Recent trends and advancements in the utilization of green composites and polymeric nanocarriers for enhancing food quality and sustainable processing
- Retraction
- Retraction of “Biosynthesis and characterization of silver nanoparticles from Cedrela toona leaf extracts: An exploration into their antibacterial, anticancer, and antioxidant potential”
- Retraction of “Photocatalytic degradation of organic dyes and biological potentials of biogenic zinc oxide nanoparticles synthesized using the polar extract of Cyperus scariosus R.Br. (Cyperaceae)”
- Retraction to “Green synthesis on performance characteristics of a direct injection diesel engine using sandbox seed oil”
Articles in the same Issue
- Research Articles
- Green polymer electrolyte and activated charcoal-based supercapacitor for energy harvesting application: Electrochemical characteristics
- Research on the adsorption of Co2+ ions using halloysite clay and the ability to recover them by electrodeposition method
- Simultaneous estimation of ibuprofen, caffeine, and paracetamol in commercial products using a green reverse-phase HPTLC method
- Isolation, screening and optimization of alkaliphilic cellulolytic fungi for production of cellulase
- Functionalized gold nanoparticles coated with bacterial alginate and their antibacterial and anticancer activities
- Comparative analysis of bio-based amino acid surfactants obtained via Diels–Alder reaction of cyclic anhydrides
- Biosynthesis of silver nanoparticles on yellow phosphorus slag and its application in organic coatings
- Exploring antioxidant potential and phenolic compound extraction from Vitis vinifera L. using ultrasound-assisted extraction
- Manganese and copper-coated nickel oxide nanoparticles synthesized from Carica papaya leaf extract induce antimicrobial activity and breast cancer cell death by triggering mitochondrial caspases and p53
- Insight into heating method and Mozafari method as green processing techniques for the synthesis of micro- and nano-drug carriers
- Silicotungstic acid supported on Bi-based MOF-derived metal oxide for photodegradation of organic dyes
- Synthesis and characterization of capsaicin nanoparticles: An attempt to enhance its bioavailability and pharmacological actions
- Synthesis of Lawsonia inermis-encased silver–copper bimetallic nanoparticles with antioxidant, antibacterial, and cytotoxic activity
- Facile, polyherbal drug-mediated green synthesis of CuO nanoparticles and their potent biological applications
- Zinc oxide-manganese oxide/carboxymethyl cellulose-folic acid-sesamol hybrid nanomaterials: A molecularly targeted strategy for advanced triple-negative breast cancer therapy
- Exploring the antimicrobial potential of biogenically synthesized graphene oxide nanoparticles against targeted bacterial and fungal pathogens
- Biofabrication of silver nanoparticles using Uncaria tomentosa L.: Insight into characterization, antibacterial activities combined with antibiotics, and effect on Triticum aestivum germination
- Membrane distillation of synthetic urine for use in space structural habitat systems
- Investigation on mechanical properties of the green synthesis bamboo fiber/eggshell/coconut shell powder-based hybrid biocomposites under NaOH conditions
- Green synthesis of magnesium oxide nanoparticles using endophytic fungal strain to improve the growth, metabolic activities, yield traits, and phenolic compounds content of Nigella sativa L.
- Estimation of greenhouse gas emissions from rice and annual upland crops in Red River Delta of Vietnam using the denitrification–decomposition model
- Synthesis of humic acid with the obtaining of potassium humate based on coal waste from the Lenger deposit, Kazakhstan
- Ascorbic acid-mediated selenium nanoparticles as potential antihyperuricemic, antioxidant, anticoagulant, and thrombolytic agents
- Green synthesis of silver nanoparticles using Illicium verum extract: Optimization and characterization for biomedical applications
- Antibacterial and dynamical behaviour of silicon nanoparticles influenced sustainable waste flax fibre-reinforced epoxy composite for biomedical application
- Optimising coagulation/flocculation using response surface methodology and application of floc in biofertilisation
- Green synthesis and multifaceted characterization of iron oxide nanoparticles derived from Senna bicapsularis for enhanced in vitro and in vivo biological investigation
- Potent antibacterial nanocomposites from okra mucilage/chitosan/silver nanoparticles for multidrug-resistant Salmonella Typhimurium eradication
- Trachyspermum copticum aqueous seed extract-derived silver nanoparticles: Exploration of their structural characterization and comparative antibacterial performance against gram-positive and gram-negative bacteria
- Microwave-assisted ultrafine silver nanoparticle synthesis using Mitragyna speciosa for antimalarial applications
- Green synthesis and characterisation of spherical structure Ag/Fe2O3/TiO2 nanocomposite using acacia in the presence of neem and tulsi oils
- Green quantitative methods for linagliptin and empagliflozin in dosage forms
- Enhancement efficacy of omeprazole by conjugation with silver nanoparticles as a urease inhibitor
- Residual, sequential extraction, and ecological risk assessment of some metals in ash from municipal solid waste incineration, Vietnam
- Green synthesis of ZnO nanoparticles using the mangosteen (Garcinia mangostana L.) leaf extract: Comparative preliminary in vitro antibacterial study
- Simultaneous determination of lesinurad and febuxostat in commercial fixed-dose combinations using a greener normal-phase HPTLC method
- A greener RP-HPLC method for quaternary estimation of caffeine, paracetamol, levocetirizine, and phenylephrine acquiring AQbD with stability studies
- Optimization of biomass durian peel as a heterogeneous catalyst in biodiesel production using microwave irradiation
- Thermal treatment impact on the evolution of active phases in layered double hydroxide-based ZnCr photocatalysts: Photodegradation and antibacterial performance
- Preparation of silymarin-loaded zein polysaccharide core–shell nanostructures and evaluation of their biological potentials
- Preparation and characterization of composite-modified PA6 fiber for spectral heating and heat storage applications
- Preparation and electrocatalytic oxygen evolution of bimetallic phosphates (NiFe)2P/NF
- Rod-shaped Mo(vi) trichalcogenide–Mo(vi) oxide decorated on poly(1-H pyrrole) as a promising nanocomposite photoelectrode for green hydrogen generation from sewage water with high efficiency
- Green synthesis and studies on citrus medica leaf extract-mediated Au–ZnO nanocomposites: A sustainable approach for efficient photocatalytic degradation of rhodamine B dye in aqueous media
- Cellulosic materials for the removal of ciprofloxacin from aqueous environments
- The analytical assessment of metal contamination in industrial soils of Saudi Arabia using the inductively coupled plasma technology
- The effect of modified oily sludge on the slurry ability and combustion performance of coal water slurry
- Eggshell waste transformation to calcium chloride anhydride as food-grade additive and eggshell membranes as enzyme immobilization carrier
- Synthesis of EPAN and applications in the encapsulation of potassium humate
- Biosynthesis and characterization of silver nanoparticles from Cedrela toona leaf extracts: An exploration into their antibacterial, anticancer, and antioxidant potential
- Enhancing mechanical and rheological properties of HDPE films through annealing for eco-friendly agricultural applications
- Immobilisation of catalase purified from mushroom (Hydnum repandum) onto glutaraldehyde-activated chitosan and characterisation: Its application for the removal of hydrogen peroxide from artificial wastewater
- Sodium titanium oxide/zinc oxide (STO/ZnO) photocomposites for efficient dye degradation applications
- Effect of ex situ, eco-friendly ZnONPs incorporating green synthesised Moringa oleifera leaf extract in enhancing biochemical and molecular aspects of Vicia faba L. under salt stress
- Biosynthesis and characterization of selenium and silver nanoparticles using Trichoderma viride filtrate and their impact on Culex pipiens
- Photocatalytic degradation of organic dyes and biological potentials of biogenic zinc oxide nanoparticles synthesized using the polar extract of Cyperus scariosus R.Br. (Cyperaceae)
- Assessment of antiproliferative activity of green-synthesized nickel oxide nanoparticles against glioblastoma cells using Terminalia chebula
- Chlorine-free synthesis of phosphinic derivatives by change in the P-function
- Anticancer, antioxidant, and antimicrobial activities of nanoemulsions based on water-in-olive oil and loaded on biogenic silver nanoparticles
- Study and mechanism of formation of phosphorus production waste in Kazakhstan
- Synthesis and stabilization of anatase form of biomimetic TiO2 nanoparticles for enhancing anti-tumor potential
- Microwave-supported one-pot reaction for the synthesis of 5-alkyl/arylidene-2-(morpholin/thiomorpholin-4-yl)-1,3-thiazol-4(5H)-one derivatives over MgO solid base
- Screening the phytochemicals in Perilla leaves and phytosynthesis of bioactive silver nanoparticles for potential antioxidant and wound-healing application
- Graphene oxide/chitosan/manganese/folic acid-brucine functionalized nanocomposites show anticancer activity against liver cancer cells
- Nature of serpentinite interactions with low-concentration sulfuric acid solutions
- Multi-objective statistical optimisation utilising response surface methodology to predict engine performance using biofuels from waste plastic oil in CRDi engines
- Microwave-assisted extraction of acetosolv lignin from sugarcane bagasse and electrospinning of lignin/PEO nanofibres for carbon fibre production
- Biosynthesis, characterization, and investigation of cytotoxic activities of selenium nanoparticles utilizing Limosilactobacillus fermentum
- Highly photocatalytic materials based on the decoration of poly(O-chloroaniline) with molybdenum trichalcogenide oxide for green hydrogen generation from Red Sea water
- Highly efficient oil–water separation using superhydrophobic cellulose aerogels derived from corn straw
- Beta-cyclodextrin–Phyllanthus emblica emulsion for zinc oxide nanoparticles: Characteristics and photocatalysis
- Assessment of antimicrobial activity and methyl orange dye removal by Klebsiella pneumoniae-mediated silver nanoparticles
- Influential eradication of resistant Salmonella Typhimurium using bioactive nanocomposites from chitosan and radish seed-synthesized nanoselenium
- Antimicrobial activities and neuroprotective potential for Alzheimer’s disease of pure, Mn, Co, and Al-doped ZnO ultra-small nanoparticles
- Green synthesis of silver nanoparticles from Bauhinia variegata and their biological applications
- Synthesis and optimization of long-chain fatty acids via the oxidation of long-chain fatty alcohols
- Eminent Red Sea water hydrogen generation via a Pb(ii)-iodide/poly(1H-pyrrole) nanocomposite photocathode
- Green synthesis and effective genistein production by fungal β-glucosidase immobilized on Al2O3 nanocrystals synthesized in Cajanus cajan L. (Millsp.) leaf extracts
- Green stability-indicating RP-HPTLC technique for determining croconazole hydrochloride
- Green synthesis of La2O3–LaPO4 nanocomposites using Charybdis natator for DNA binding, cytotoxic, catalytic, and luminescence applications
- Eco-friendly drugs induce cellular changes in colistin-resistant bacteria
- Tangerine fruit peel extract mediated biogenic synthesized silver nanoparticles and their potential antimicrobial, antioxidant, and cytotoxic assessments
- Green synthesis on performance characteristics of a direct injection diesel engine using sandbox seed oil
- A highly sensitive β-AKBA-Ag-based fluorescent “turn off” chemosensor for rapid detection of abamectin in tomatoes
- Green synthesis and physical characterization of zinc oxide nanoparticles (ZnO NPs) derived from the methanol extract of Euphorbia dracunculoides Lam. (Euphorbiaceae) with enhanced biosafe applications
- Detection of morphine and data processing using surface plasmon resonance imaging sensor
- Effects of nanoparticles on the anaerobic digestion properties of sulfamethoxazole-containing chicken manure and analysis of bio-enzymes
- Bromic acid-thiourea synergistic leaching of sulfide gold ore
- Green chemistry approach to synthesize titanium dioxide nanoparticles using Fagonia Cretica extract, novel strategy for developing antimicrobial and antidiabetic therapies
- Green synthesis and effective utilization of biogenic Al2O3-nanocoupled fungal lipase in the resolution of active homochiral 2-octanol and its immobilization via aluminium oxide nanoparticles
- Eco-friendly RP-HPLC approach for simultaneously estimating the promising combination of pentoxifylline and simvastatin in therapeutic potential for breast cancer: Appraisal of greenness, whiteness, and Box–Behnken design
- Use of a humidity adsorbent derived from cockleshell waste in Thai fried fish crackers (Keropok)
- One-pot green synthesis, biological evaluation, and in silico study of pyrazole derivatives obtained from chalcones
- Bio-sorption of methylene blue and production of biofuel by brown alga Cystoseira sp. collected from Neom region, Kingdom of Saudi Arabia
- Synthesis of motexafin gadolinium: A promising radiosensitizer and imaging agent for cancer therapy
- The impact of varying sizes of silver nanoparticles on the induction of cellular damage in Klebsiella pneumoniae involving diverse mechanisms
- Microwave-assisted green synthesis, characterization, and in vitro antibacterial activity of NiO nanoparticles obtained from lemon peel extract
- Rhus microphylla-mediated biosynthesis of copper oxide nanoparticles for enhanced antibacterial and antibiofilm efficacy
- Harnessing trichalcogenide–molybdenum(vi) sulfide and molybdenum(vi) oxide within poly(1-amino-2-mercaptobenzene) frameworks as a photocathode for sustainable green hydrogen production from seawater without sacrificial agents
- Magnetically recyclable Fe3O4@SiO2 supported phosphonium ionic liquids for efficient and sustainable transformation of CO2 into oxazolidinones
- A comparative study of Fagonia arabica fabricated silver sulfide nanoparticles (Ag2S) and silver nanoparticles (AgNPs) with distinct antimicrobial, anticancer, and antioxidant properties
- Visible light photocatalytic degradation and biological activities of Aegle marmelos-mediated cerium oxide nanoparticles
- Physical intrinsic characteristics of spheroidal particles in coal gasification fine slag
- Exploring the effect of tea dust magnetic biochar on agricultural crops grown in polycyclic aromatic hydrocarbon contaminated soil
- Crosslinked chitosan-modified ultrafiltration membranes for efficient surface water treatment and enhanced anti-fouling performances
- Study on adsorption characteristics of biochars and their modified biochars for removal of organic dyes from aqueous solution
- Zein polymer nanocarrier for Ocimum basilicum var. purpurascens extract: Potential biomedical use
- Green synthesis, characterization, and in vitro and in vivo biological screening of iron oxide nanoparticles (Fe3O4) generated with hydroalcoholic extract of aerial parts of Euphorbia milii
- Novel microwave-based green approach for the synthesis of dual-loaded cyclodextrin nanosponges: Characterization, pharmacodynamics, and pharmacokinetics evaluation
- Bi2O3–BiOCl/poly-m-methyl aniline nanocomposite thin film for broad-spectrum light-sensing
- Green synthesis and characterization of CuO/ZnO nanocomposite using Musa acuminata leaf extract for cytotoxic studies on colorectal cancer cells (HCC2998)
- Review Articles
- Materials-based drug delivery approaches: Recent advances and future perspectives
- A review of thermal treatment for bamboo and its composites
- An overview of the role of nanoherbicides in tackling challenges of weed management in wheat: A novel approach
- An updated review on carbon nanomaterials: Types, synthesis, functionalization and applications, degradation and toxicity
- Special Issue: Emerging green nanomaterials for sustainable waste management and biomedical applications
- Green synthesis of silver nanoparticles using mature-pseudostem extracts of Alpinia nigra and their bioactivities
- Special Issue: New insights into nanopythotechnology: current trends and future prospects
- Green synthesis of FeO nanoparticles from coffee and its application for antibacterial, antifungal, and anti-oxidation activity
- Dye degradation activity of biogenically synthesized Cu/Fe/Ag trimetallic nanoparticles
- Special Issue: Composites and green composites
- Recent trends and advancements in the utilization of green composites and polymeric nanocarriers for enhancing food quality and sustainable processing
- Retraction
- Retraction of “Biosynthesis and characterization of silver nanoparticles from Cedrela toona leaf extracts: An exploration into their antibacterial, anticancer, and antioxidant potential”
- Retraction of “Photocatalytic degradation of organic dyes and biological potentials of biogenic zinc oxide nanoparticles synthesized using the polar extract of Cyperus scariosus R.Br. (Cyperaceae)”
- Retraction to “Green synthesis on performance characteristics of a direct injection diesel engine using sandbox seed oil”